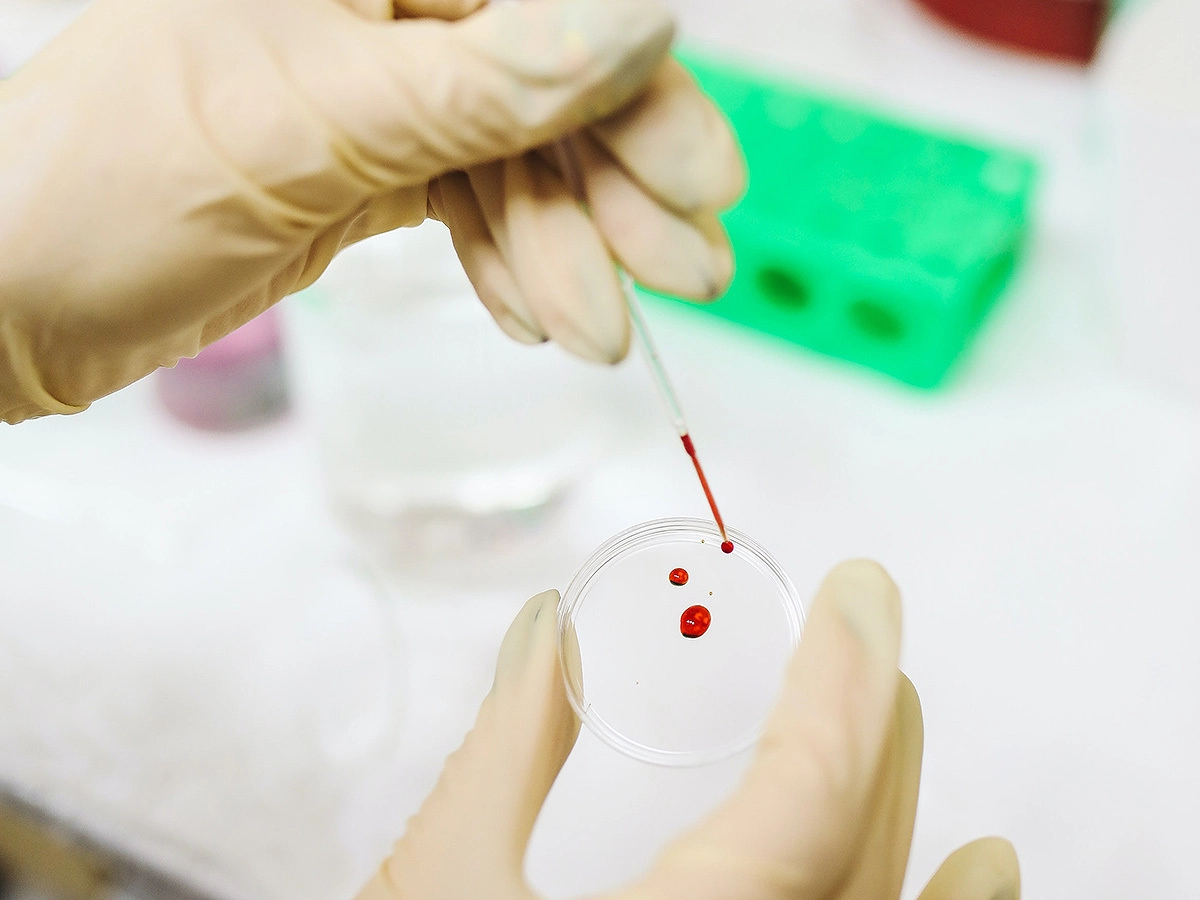

Роботы в крови: hi-tech-медицина может обернуться биотерроризмом
- 06 октября 2020 00:39
- Василий Зырянов
В кровотоке путешествует колония одушевленных машин размером в несколько нанометров. Будучи наделенной феноменальным командным интеллектом и чувствительностью, она устремляется к печени, где было зафиксировано неестественное деление клеток. Получившие тревожный сигнал роботы окружают целевую область. Казалось бы, сейчас они решат проблему, но нет: что-то идет не так. Вместо этого рой нанохирургов спешит к сердцу, где блокирует один из его клапанов, и пациент перестает дышать. Кто-то изменил их назначение, быстро перепрограммировав из целителей в убийц. Звучит как вымысел выжившего из ума фантаста? Отчасти да…
Как фантастика стала былью
В 2015 году The Wall Street Journal, фактически один из генераторов и направляющих мнений, пугал читателей механическими пауками или минидронами, которые могут забраться в душевую комнату и как бы невзначай ввести человеку дозу яда. На один шаг ближе к разговорам о колониях нанороботов, на полшага — к циркуляции этих колоний вместе с кровотоком. Но что это — биороботы? Что им делать в густой крови?
Это управляемые и программируемые объекты. Они могут походить на живые ткани, но созданные искусственно. Чаще биороботы — это объекты микромира. Их конструкция должна включать микроскопические рычаги, чтобы они могли удалять или перемещать объекты внутри тела. Предполагается, что биороботы смогут выступать как заменители натуральных клеток (ниже поговорим о респироцитах), подменяя их функции, либо как сверхсложный инструмент хирурга. В ближайшее десятилетие они станут главным трендом обновленной медицины.
Научные работы, посвященные наноагентам, точечно доставляющим противораковые препараты, публикуются регулярно. Взять, к примеру, «Применение основанных на хитозане наноносителей в точечной доставке противоопухолевых препаратов» (англ. «Application of Chitosan-Based Nanocarriers in Tumor-Targeted Drug Delivery»). Длинное и сложное название. Однако суть в том, что вместо поражающих в том числе и здоровые ткани препаратов можно использовать изощренную технологию доставки, при которой живая и здоровая ткань остается нетронутой.
Речь идет о неодушевленных, не наделенных рассудком молекулах, о дирижируемом законами органической химии потоке веществ. Но проблема точечного оперирования структурами там, где скальпель бессилен или слишком велик, поднимается четко и ясно. Начало положено, путь есть.
Как уничтожить рак
В перспективе управляемые стайки нанороботов смогут «вырезать» пораженные клетки, таким образом, подводя жирную черту под главным вопросом онкологии: как окончательно уничтожить рак.
В 2015 году Американское химическое общество опубликовало важный релиз. В нем говорится, что микроскопические роботы могут выполнять высокоточные хирургические операции, удалять рак, восстанавливать ткани и прочее. И самое важное: как нанороботы смогут путешествовать по кровотоку под воздействием магнетической силы. Вопросы о том, можно ли впускать в кровоток инородные тела, как они будут выглядеть, уже не стоят. Рассматривается лишь нюанс: как им двигаться в густой крови.
И вот ответ: ученые сплели нановолокно из нити полимера и двух магнитных участков. Поместив их в плотный раствор, они направляли волокно магнитами, и то двигалось по S-образной траектории. Расчетная скорость, оказалось, была равна «одной длине тела человека в секунду». Дж. И. Рейх, писавшая в Tech Times о нанопловцах (буквально), как раз сравнивала невидимых роботов с минидронами и походя иронизировала, что те «в одночасье захватят весь мир и убьют нас всех».
Сотворение красных кровяных телец
Что будет, если насытить кровь человека эритроцитами? Увеличится поглощение углекислого газа, скорость и объем доставки кислорода. Объем вырастет в 236 раз. Что это значит? Границы физических возможностей бесконечно раздвинутся. Это делает возможным, например, заплыв под водой без маски на протяжении двух часов. Заманчивая перспектива. Между тем красные кровяные тельца уже можно чуть ли не напечатать на 3D-принтере: нужен лишь молекулярный сборщик. В 2013 году Abbott Laboratories в Чикаго уже тестировала роботизированные респироциты (англ. Respirocytes), то есть аналоги эритроцитов, на крысах.
Сколько времени еще осталось существовать грани между смелой фантазией и реальностью? Концепт респироцита предложил Роберт Фрайтас в 1998 году. Утверждается, что они войдут в медицинскую практику до 2028 года.
Изощренный террор на острие прогресса
Тот же The Wall Street Journal в статье «Новые законы для новых угроз — дронов и биотерроризма» рассуждал: что мешает, допустим, радикальному анархисту с багажом знаний микробиолога воскресить в пробирке ДНК чумы образца XIV века?
Для этого нужно лишь иметь мощный интеллект, способный жонглировать комбинациями генов. И что мешает ему использовать это коварное и, очевидно, трусливое оружие?
Зададим схожий вопрос. Если сейчас нанороботы в крови рассматриваются в сугубо человеколюбивом контексте, то что мешает преступным умам со временем вывернуть наизнанку этот контекст, сделав его мизантропическим? Во-первых, ввести колонию послушных крошек-лекарей просто: это вопрос одной инъекции. Во-вторых, их напору невозможно сопротивляться. Речь ведь даже не о хирургической точности. Раны от них невозможно залечить, потому что их нельзя увидеть. Более того, сложно понять, что вообще происходит. Орган перестает работать, и все. Ткани организма распарываются по швам, и ничего не поделаешь. Возможно, у этики, особенно медицинской, есть решение этой проблемы?
Схоластика технократического века
Помните, средневековые схоласты любили спорить: «Сколько ангелов поместится на кончике иглы?» А биороботов? Робототехника, в сущности, — лезвие в руках медицинского прогресса. Это один из фронтов, где консервативные и местами устаревшие практики уходят за кулисы, а невообразимые раньше технологии выходят на сцену. Сказать, что этим лезвием медицина будет препарировать будущее, не совсем верно. Она уже его вежливо и деликатно препарирует, но так, чтобы общество не переживало массовый шок, а переваривало открытия порцию за порцией. Мир меняется. Этика не успевает приспособиться к космическим скоростям технологий, сотрясающим само ее основание, как в случае с роботами в кровотоке. Не успевает приспособиться и право.
Современные законы требуют корректировки, чтобы в будущем рассматривать, например, вопросы вмешательства машин в метаболические процессы. Обеспокоенность возможными последствиями прогресса в массовом сознании еще не так велика. Во многом потому, что в реальность перспектив мало кто искренне верит. Прогресс, как принято говорить, дает одной рукой благо, другой же отбирает его. Механический респироцит, специальный агент дыхания, расширяет горизонт скромных возможностей человека на сотню пунктов. Но кто может сказать, что он безопасен? Ведь скальпелем оперирует и хирург, спасая человека, и преступник, лишая его жизни.
- Телеграм
- Дзен
- Подписывайтесь на наши каналы и первыми узнавайте о главных новостях и важнейших событиях дня.

Войти через социальные сети: